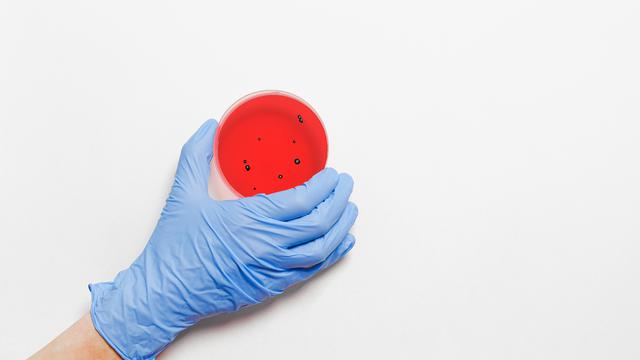

Varian Mu, Lambda, C.12, Mana yang Paling Berbahaya?
Virus corona yang mewabah sejak akhir tahun 2019 silam memang tidak henti-hentinya memberikan kejutan bagi masyarakat, salah satunya varian virus yang semakin berkembang. Kalau sebelumnya sudah Mu, Lambda, dan C.1.2.
Meski belum ditemukan di Indonesia, namun ketiga varian tersebut tetap harus diwaspadai. Mengingat, ada kemungkinan besar varian Mu, Lambda, dan C.1.2 juga akan terdeteksi di Indonesia – sama seperti varian sebelumnya.
Mengenai ketiga varian baru Covid-19, lantas apa saja perbedaan di antara ketiganya? Dan, manakah yang paling berbahaya? Untuk ulasan lengkapnya, simak di bawah ini!
Varian Mu
Credit Image - liputan6.com
Varian yang satu ini pertama kali ditemukan di Kolombia pada bulan Januari 2021 silam. Disebut sebagai varian Mu, ini disebut punya potensi transmisi yang cukup tinggi, hampir sama dengan varian Delta yang juga mudah menular. Bahkan, Organisasi Kesehatan Dunia (WHO) pun sudah memasukkan varian Mu dalam kategori variant of interest (VOI).
Variant of interest merupakan kategori yang diartikan ada indikasi varian memiliki mutasi yang bisa memengaruhi sifat penularan, kepekaan alat tes, keparahan gejala, hingga kemampuan virus dalam menghindari sistem imunitas.
Saat ini, varian Mu sudah terdeteksi di 49 negara, bahkan disebut dikhawatirkan dapat menghindari sebagian kekebalan yang dikembangkan usai terinfeksi virus – maupun setelah mendapat vaksin Covid-19.
Dikatakan bahwa varian Mu memiliki sekelompok mutasi yang membuatnya kurang rentan terhadap perlindungan kekebalan. Dari informasi yang diberikan WHO, varian Mu disebut punya konstelasi mutasi yang menunjukkan sifat potensial untuk lolos dari sistem kekebalan yang telah terbentuk.
Selain itu, disebutkan juga bahwa varian Mu bisa menghindari pertahanan kekebalan dengan cara yang mirip dengan B.1.351 atau varian Beta – yakni, varian yang pertama kali ditemukan di Afrika Selatan. Namun, ungkapan tersebut masih memerlukan penelitian yang lebih lanjut.
Yang dikhawatirkan dari varian Mu adalah mutasi yang dibawanya, seperti P681H, yang juga ditemukan pada B.1.1.7 atau varian Alpha, dan dikaitkan dengan transmisi yang lebih cepat. Mutasi lainnya adalah E484K dan K417N yang membantu virus menghindari pertahanan kekebalan.
Bagaimana Dengan Varian Lambda?

Credit Image - kompas.com
Selanjutnya, ada pula varian Lambda yang patut diwaspadai. Varian yang juga disebut sebagai C.37 ini pertama kali ditemukan di Peru pada Desember 2020. Efek mutasi dari virus yang satu ini meliputi penurunan kemampuan netralisasi serum natural, maupun yang diinduksi vaksin, serta jenis tertentu antibodi monoklonal.
Sejauh ini, varian Lambda juga sudah dimasukkan ke dalam kategori variant of interest – dan sudah berhasil menyebar di 42 negara. Meski demikian, belum ada laporan lanjutan mengenai tingkat keparahan yang ditimbulkan.
Varian C.1.2

Credit Image - cnnindonesia.com
Dan yang terakhir, ada varian C.1.2 yang ditemukan pertama kali di Afrika Selatan – di bulan Mei 2021 silam. Sama seperti kedua varian lainnya, varian C.1.2 diduga dapat meningkatkan kemampuan transmisi, serta menghindari kerja sistem imunitas manusia.
Namun, mengenai tingkat transmisi yang dimiliki varian yang satu ini, masih diperlukan penelitian lebih lanjut untuk membuktikannya. Selain itu, varian C.1.2 juga belum masuk ke kategori variant of concern – atau varian of interest. Tetapi, varian ini tetap harus diwaspadai, karena sekarang sudah ditemukan di 9 negara.
Apa Langkah yang Bisa Dilakukan?

Credit Image - ilovelife.co.id
Di masa pandemi Covid-19, cara paling tepat untuk meminimalisir risiko terinfeksi virus, yakni dengan menerapkan protokol kesehatan – sekaligus menjaga kesehatan tubuh, sehingga kekebalan dapat bekerja secara optimal.
Pastikan sudah memakai masker ketika bepergian – direkomendasikan menggunakan masker ganda, menerapkan jaga jarak, rutin mencuci tangan, menghindari kerumunan, serta tidak bepergian – kecuali ada urusan yang mendesak.
Selain itu, optimalkan perlindungan diri dengan menerapkan pola hidup sehat, seperti Enervon Active.
Konsumsi Enervon-C yang mengandung Vitamin C, Vitamin B Kompleks (Vitamin B1, Vitamin B2, Vitamin B6, dan Vitamin B12), Niacinamide, dan Kalsium Pantotenat – yang dapat menjaga daya tahan tubuhmu agar tidak mudah sakit.
Minum Enervon-C Effervescent dengan kandungan Vitamin C 1000 mg untuk memberikan perlindungan ekstra, sekaligus mampu membuat tubuh terasa lebih segar sepanjang hari.
Untuk yang memiliki masalah lambung sensitif, direkomendasikan minum Enervon Active yang mengandung non-acidic Vitamin C 500 mg, Vitamin B Kompleks (Vitamin B1, Vitamin B2, Vitamin B6, Vitamin B12), Niacinamide, Kalsium Pantotenat, dan Zinc – yang dapat membantu menjaga stamina agar tak mudah lelah, sekaligus optimalkan sistem kekebalan tubuh.
Tak hanya membantu menjaga kekebalan saja, namun kandungan vitamin B kompleks dalam Enervon-C dan Enervon Active juga dapat membantu proses metabolisme, sehingga makanan yang kamu konsumsi dapat diubah menjadi sumber energi yang lebih tahan lama. Jadi, tak perlu khawatir tubuh mudah lelah, ya!
Untuk mendapatkan sejumlah produk multivitamin Enervon yang asli, pastikan kamu membelinya dari official store di Tokopedia, Shopee, Lazada, dan BukaLapak. Atau kunjungi drug store dan apotek terdekat di daerahmu.
Itulah ulasan mengenai ketiga varian Covid-19 terbaru. Walaupun belum terdeteksi di Indonesia, namun varian Mu, Lambda, dan C.1.2 tetap harus diwaspadai, mengingat adanya kemungkinan varian virus tersebut juga mudah menular.
Featured Image - wric.com
Source - detik.com





